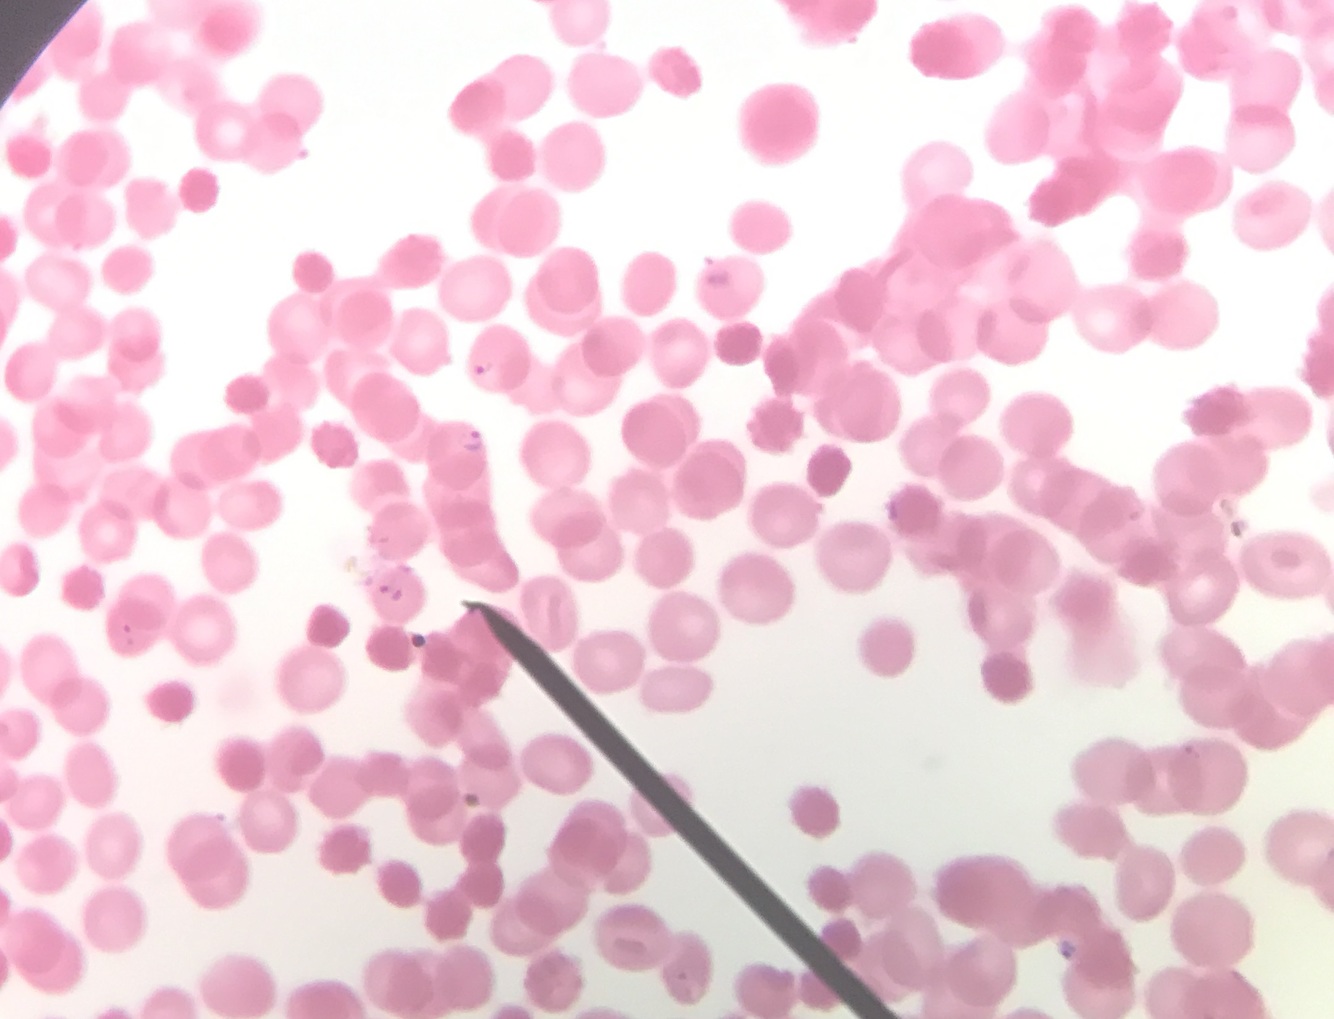

Fungi:Penicillium
conidia + conidiophores

Fungi:Aspergilles

Fungi: aspergillus
condiaphores

Fungi:Rhizopus
sporangia
zygospores

Fungi: Rhizopus
nigricons
congugation

Fungi:Penicillum
conidia

Fungi: Rhizopus
sporangia

Fungi:Rhizopus
Coniugation

Fungi:Rhizopus
zygospores

Protozoa: Balantidium coli trophozites

Protozoa:Clonorchis sinensis

Protozoa:Trypanosoma rhodesiense

Protozoa:Schistosoma mansoni

Protozoa:trypanosoma gambiense

Fungi:sporangia
zygotes

Protozoa:Trichuris
egg

Protozoa:Trichomonas
vagoma smear

Protozoa:Leishmania
donovani culture smear
Protozoa:plasmodium falciparum

Protozoa:Balantidium

Glardia lamblia cysts

schistosoma mansoni eggs

Trichinella spiralis

cryptosporidium
parvum
coccidian